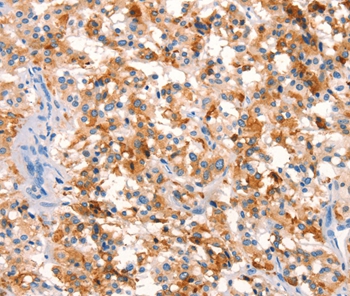
Anti-SPRN Antibody

SPRN Antibody - C-terminal region (OAAB02172)
OAAB02172
ApplicationsWestern Blot, ImmunoHistoChemistry
Product group Antibodies
ReactivityHuman, Mouse
TargetSPRN
Overview
- SupplierAviva Systems Biology
- Product NameSPRN Antibody - C-terminal region (OAAB02172)
- Delivery Days Customer23
- ApplicationsWestern Blot, ImmunoHistoChemistry
- CertificationResearch Use Only
- ClonalityPolyclonal
- Concentration0.5 mg/ml
- FormatPurified polyclonal antibody supplied in PBS with 0.09% (W/V) sodium azide. This antibody is purified through a protein A column, followed by peptide affinity purification.
- Gene ID503542
- Target nameSPRN
- Target descriptionshadow of prion protein
- Target synonymsSHADOO, SHO, bA108K14.1, shadow of prion protein, hypothetical protein BC004409, protein shadoo, shadow of prion protein homolog
- HostRabbit
- IsotypeIgG
- ReactivityHuman, Mouse
- Storage Instruction2°C to 8°C,-20°C
- UNSPSC12352203